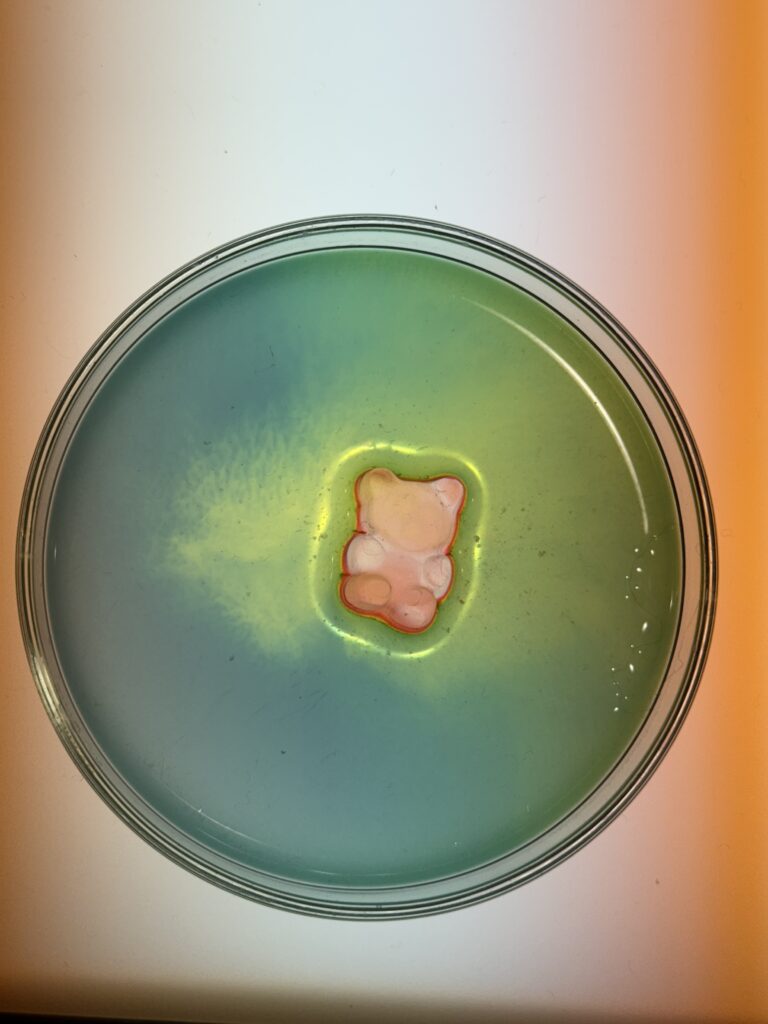
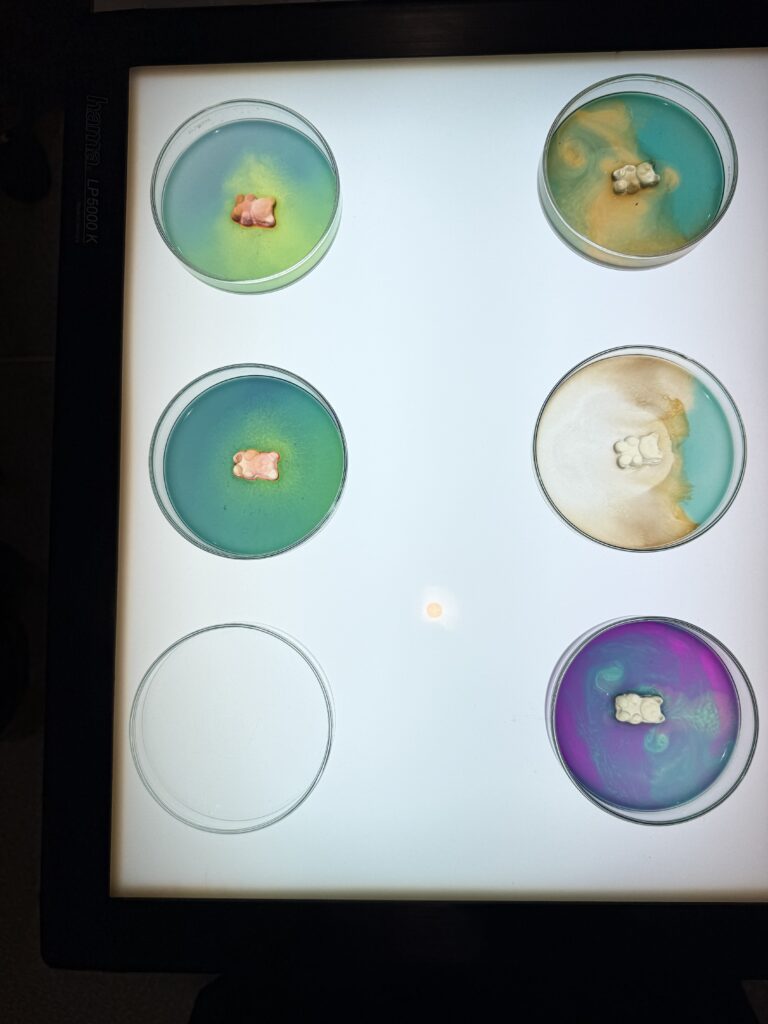

MINT-Informationen
MINT am MN
Die Abteilung Mathematik und Naturwissenschaften (MN) des Gymnasiums Neufeld bietet den MINT-interessierten Schüler*innen die Schwerpunktfächer «Biologie und Chemie (BC)» und «Physik und Anwendungen der Mathematik (PAM)» an.


Im Schulalltag fördern wir MINT in Halbklassenpraktika sowohl in Grundlagen- als auch Schwerpunktfächern, MINT-Exkursionen, Schwerpunktfach- und Ergänzungsfachwochen (GYM3 in den Kalenderwochen 38 bzw. 27), Veranstaltungen mit Universitäten (ETH unterwegs, EPFL Summer School, Brain Week, MINT-Tag der Universität Bern, dem Schülerstudium an der Universität Bern) sowie am TecDay in Zusammenarbeit mit der SATW für FMS- und GYM-Schüler*innen (ausser FMS3 und GYM4).
MINT-interessierte Schüler*innen des Gymnasiums Neufeld besuchen regelmässig naturwissenschaftlich orientierte Studienwochen im Rahmen von «Schweizer Jugend forscht» und nehmen an entsprechenden Forschungswettbewerben teil. Zudem nehmen etliche unserer Gymnasiast*innen erfolgreich an Wissenschaftsolympiaden teil.


Wir fördern unsere Schüler*innen ab dem Schuljahr 2025/26 mit noch mehr MINT:
Auf den Stufen GYM2 und GYM3 führen die MINT-Fachschaften der Abteilung MN neu das Freifach MINT (montags, 2 Lektionen, 17:20–19:00 Uhr) mit vier aufeinanderfolgenden, fächerübergreifenden, interdisziplinären und projektartigen MINT-Modulen (I-IV) durch. Jedes Modul dauert kompakt 7 Wochen. Die Schüler*innen widmen sich in interessenbezogenen Gruppen spezifischen MINT-Fragen und arbeiten mit einer praxisorientierten Forschungshaltung.



Neu bietet die Abteilung MN das MINT-Diplom an. Im Testatheft sammeln die Schüler*innen ab Jahrgang 26M MINT-Punkte für ihre MINT-Aktivitäten. Wenn sie 100 Punkte oder mehr erreichen, erhalten sie ihr MINT-Diplom an der Maturafeier. Die beste MINT-Matura zeichnen wir mit dem MINT-Preis aus.
Die Abteilung MN ist stolze Trägerin des MINT-Labels der Akademie der Wissenschaften (SCNAT). Immer, wenn wir kommunizieren, strahlt das MINT-Label; bei Elternabenden, am Tag der offenen Tür, bei Austauschen mit der Sekundarstufe I oder den Universitäten.
Das MINT-Label steht für unsere Bemühungen in den Bereichen Mathematik, Informatik, Naturwissenschaften und Technik während der letzten Jahre.
Wir freuen uns sehr darüber, immer mehr Schüler*innen für MINT zu begeistern.
MINT: Mathematik-Informatik-Naturwissenschaften-Technik
An der Abteilung Mathematik und Naturwissenschaften des Gymnasiums Neufeld werden die beiden Schwerpunktfächer «Biologie und Chemie (BC)» bzw. «Physik und Anwendungen der Mathematik (PAM)» angeboten. Der Unterricht findet grundsätzlich in schwerpunktfachreinen Klassen statt. Mit dem mathematisch-naturwissenschaftlichen (MINT-) Fokus des Unterrichts, der Integration von ICT bzw. modernen Informatikmitteln im Unterricht und fakultativen Angeboten zur (erweiterten) Programmierung wird den Anforderungen der Berufsfelder Ingenieurwesen, Naturwissenschaften und Medizin Rechnung getragen.
Selbstständiges praktisches Arbeiten in grosszügiger und moderner Infrastruktur erlaubt es den Jugendlichen, ihre Neugierde und ihr Interesse an naturwissenschaftlichen Phänomenen auszuleben und fördert die Freude am Forschen und Experimentieren. Exkursionen und Blockwochen zu naturwissenschaftlichen Themen finden ebenso statt wie ein aktiver Praxisbezug in Form von Besuchen und/oder Zusammenarbeit mit Universitäten, ETH, EPFL, Schweizerischen Akademie der Technischen Wissenschaften (SATW) oder der Akademie der Wissenschaften (SCNAT).



Eindrücke der MINT-Fachschaften der Abteilung MN am Tag der offenen Tür, 16. Oktober 2025
Abteilung MN – die MINT-Abteilung
Die Profillektion sowie die Sonderveranstaltungen unterstützen das Leitbild der Abteilung und sind auf die Interessen, die Bedürfnisse und die spätere Studienwahl der Schüler*innen ausgerichtet. Indem wir die gemäss kantonalem Lehrplan (Lehrplan 17 für den gymnasialen Bildungsgang) vorgesehenen Profillektionen den naturwissenschaftlichen Schwerpunktfächern BC und PAM zuordnen (siehe Lektionentafel), möchten wir sicherstellen, dass unsere Maturandinnen und Maturanden sehr gut auf von ihnen bevorzugt gewählten Studien aus dem MINT-Bereich vorbereitet sind.

Eindrücke der MINT-Fachschaften der Abteilung MN am Tag der offenen Tür, 16. Oktober 2025
MINT-Förderung
An der Abteilung MN wird eine zusätzliche Profillektion eingesetzt, um die im Rahmen des regulären Lehrplans erworbenen Kenntnisse und Fähigkeiten zu vertiefen und so gezielter auf Studiengänge im MINT- und medizinischen Bereich vorbereitet zu sein. In Praktika bzw. experiment- und methodenorientiertem Unterricht erhalten unsere Schüler*innen zudem einen qualifizierten Einblick in die naturwissenschaftliche Arbeitsweise.
Praktika Grundlagen- und Schwerpunktfach in Halbklassen
Schüler*innen werden durch experimentelle Erfahrungen an die Methoden der Naturwissenschaften herangeführt. Sie lernen experimentelle Phänomene zu deuten und Resultate zu interpretieren. Die grosszügige und moderne Infrastruktur am Gymnasium Neufeld (zusätzlich zum Unterrichtsraum steht gleichzeitig ein Labor zur Verfügung) ermöglicht einen naturwissenschaftlich hochstehenden, projektbezogenen und interdisziplinären Unterricht, welcher sich an den Anforderungen des wissenschaftlichen Arbeitens an Hochschulen orientiert. Die örtliche Nähe und das gute Einvernehmen mit der Universität Bern (Biologie, Chemie, Exakte Wissenschaften, Pharmazie, IBM, TKI etc.) spielt dabei eine zentrale Rolle.
MINT-Sonderveranstaltungen
Exkursionen (ein- und mehrtägig)
Auf den Exkursionen erleben die Schüler*innen den Bezug zur Praxis. In den naturwissenschaftlichen Fächern finden sie regelmässig in Zusammenarbeit mit universitären Instituten und technischen Hochschulen bzw. der Industrie statt.
Praktika (siehe oben)
In den Praktika der naturwissenschaftlichen Grundlagenfächer und der Schwerpunktfächer Physik/Anwendungen der Mathematik bzw. Biologie/Chemie führen die Schüler*innen selbst Versuche durch und gewinnen so Erkenntnisse in praktischem, wissenschaftlichem Arbeiten.




Halbes Dodekaeder, Dodekaeder, Stern und Vitrine mit Körpern:
Anwendungen der Mathematik mit der Klasse 25Md
Schwerpunktfach- und Ergänzungsfachwoche (KW 38 bzw. 27)
In der Schwerpunktfachwoche auf Stufe GYM3 in der Woche vor den Herbstferien (Kalenderwoche 38) haben die Schüler*innen die Möglichkeit, sich in weitere, spannende MINT-Themen einzuarbeiten und so ihre Fähigkeiten weiterzuentwickeln. Die Ergänzungsfachwoche ist ein wichtiger Bestandteil des Unterrichts und dient der länger dauernden, intensiven Beschäftigung mit Problemkreisen, welche sich aus MINT-spezifischen Fragestellungen ergeben. In beiden Wochen erfolgt der Unterricht stark projektbezogen.






Ergänzungsfach Informatik auf Stufe GYM3, Oktober 2025 :
Bau einer Useless Machine



Schwerpunktfachwoche Physik und Anwendungen der Mathematik GYM3 KW 38, 2025:
Flugbahn einer Rakete berechnen









Schwerpunktfachwoche Physik und Anwendungen der Mathematik GYM3 KW 38, 2024:
Solartracker bauen



Schwerpunktfachwoche Physik und Anwendungen der Mathematik GYM3 KW 38, 2023:
Sonnenuhren bauen, am PSI und im HF Labor Metas
Gemeinsame Veranstaltungen mit Hochschulen
Verteilt über das ganze gymnasiale Curriculum finden wiederholt Veranstaltungen mit Hochschulen hinsichtlich eines Studiums im MINT-Bereich statt:
In Zusammenarbeit mit der ETH Zürich (ETHZ)
Alle zwei Jahre gastiert die ETH Zürich am Gymnasium Neufeld im Rahmen des Projekts «ETH unterwegs» und ermöglicht so unseren Schüler*innen einen realistischen Einblick in MINT-bezogene Studienfächer wie Ingenieurwissenschaften.
Jeweils im Juni finden für Gymnasiast/innen zwischen 16 und 19 Jahren die Studienwochen an der ETH statt: Biologie, Erdwissenschaften, Ingenieurwissenschaften, Mathematik und Physik. Die Schüler*innen werden dafür vom Normalunterricht dispensiert. Eine Teilnahme ist in jedem Schuljahr möglich.

ETH unterwegs, Brückenbau Wettbewerb, Februar 2024
In Zusammenarbeit mit der ETH in Lausanne (EPFL)
In Zusammenarbeit mit der EPFL und dem Gymnasium Kirchenfeld bieten wir eine Woche «Summer School» an: Wer Grundlagen zum Programmieren beherrscht, vertieft in den modernen Labors der EPFL unter der professionellen Leitung von Professor Mondada seine Kenntnisse zu künstlicher Intelligenz und zu Robotik.
In Zusammenarbeit mit der Universität Bern
An der Uni Bern gibt es ein Begabtenförderungsprogramm für Schüler*innen der zwei letzten gymnasialen Jahre. Solche SuS besuchen eine oder zwei Vorlesungen an der Uni und können auch die entsprechenden Prüfungen ablegen. Die ECTS-Punkte werden an ein Studium derselben Richtung angerechnet.
SJF-Studienwochen
Schüler*innen des Gymnasiums Neufeld besuchen regelmässig naturwissenschaftlich orientierten Studienwochen im Rahmen von «Schweizer Jugend forscht» und nehmen an entsprechenden Forschungswettbewerben teil.
Wissenschaftsolympiaden
Etliche unserer Gymnasiastinnen und Gymnasiasten nehmen, ermuntert und begleitet von unseren Lehrpersonen, an Wissenschaftsolympiaden teil. Schüler*innen werden für die Vorbereitungswochen und die Wettkämpfe dispensiert.